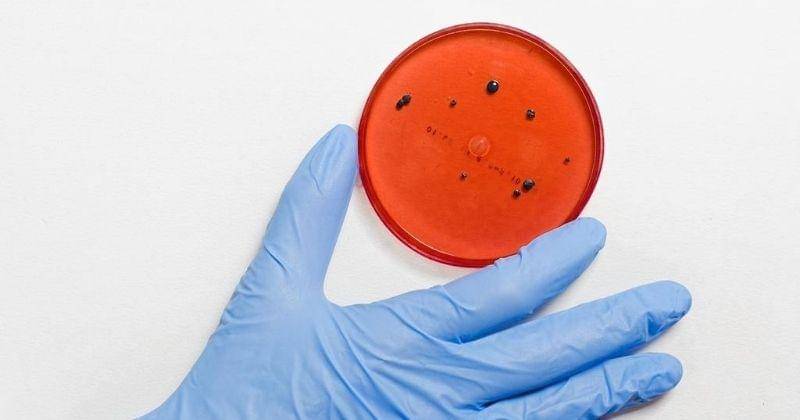
Pexels/Anna Shvets

- Nyeri tubuh
- Kelenjar getah bening yang bengkak
- Sakit kepala
- Demam
- Kelelahan
Barli Asmara Meninggal Akibat Radang Otak Karena Virus Toksoplasma

Desainer kondang tanah air, Barli Asmara meninggal dunia di usianya yang ke 42 tahun. Kabar tersebut pertama kali datang dari Instagram para selebriti yang merupakan rekan Barli Asmara.
Ada beberapa spekulasi penyebab kematian Barli Asmara. Sebelumnya, pihak manajemen menyebut bahwa Barli mengidap penyakit lambung yang sudah lama ia derita. Kemudian, keluarga Barli yang dikutip dari berbagai sumber menyebut bahwa ia terkena radang otak karena virus Toksoplasma.
Apa itu virus Toksoplasma dan mengapa bisa menyebabkan radang otak? Berikut Popmama.com rangkum Informasi lengkapnya.
1. Barli Asmara meninggal karena radang otak

Dikutip dari berbagai sumber, desainer Barli Asmara dikonfirmasi meninggal karena radang otak akibat virus Toksoplasma.
Hal itu dikonfirmasi oleh keluarga Barli Asmara sendiri. Sebelumnya, pihak manajemen Barli menyebut ia juga sudah lama menderita penyakit lambung. Diketahui, sebelum menghembuskan napas terakhir, Barli sempat dirawat di rumah sakit selama 2 minggu.
2.Apa itu virus toksoplasma dan infeksi toksoplasmosis?
Virus toksoplasma adalah virus yang bisa menyebabkan toksoplasmosis. Melansir dari Mayo Clinic, toksoplasmosis adalah penyakit yang berasal dari infeksi parasit Toxoplasma gondii.
Virus toksoplasma ini bisa masuk ke dalam tubuh manusia karena makan daging kurang matang/ mentah, kotoran kucing, dan bisa ditularkan dari Mama ke janin saat hamil.
Bagi beberapa orang toksoplasmosis dapat menyebabkan gejala seperti flu, tetapi kebanyakan orang yang terkena virus ini tidak pernah menunjukkan gejala sama sekali.
Untuk bayi yang lahir dari Mama yang terinfeksi virus toksoplasma dan orang dengan sistem kekebalan tubuh yang lemah, toksoplasmosis dapat menyebabkan komplikasi serius. Hal ini juga berlaku untuk ibu hamil yang terinfeksi virus toksoplasma.
3. Asal dan penyebab infeksi virus toksoplasma

Toxoplasma gondii (T. gondii) adalah organisme parasit bersel tunggal yang dapat menginfeksi hewan dan burung. Organisme ini juga ditemukan pada kotoran kucing.
Bersentuhan dengan kotoran kucing yang mengandung parasit sehingga memungkinkan Mama tidak sengaja menelan parasit tersebut ketika menyentuh mulut. Virus ini juga bisa berkembang pada daging mentah atau daging yang dimasak kurang matang.
Oleh karenanya siapa pun bisa terinfeksi virus toksoplasma ini. Namun, risiko komplikasi virus ini lebih berbahaya untuk beberapa orang dengan kasus seperti HIV/AIDS, orang yang menjalani kemoterapi, atau orang yang menjalani pengobatan steroid dan pengobatan lain yang menyebabkan sistem kekebalan tubuh menurun.
4. Gejala orang yang terinfeksi toksoplasma

Kebanyakan orang sehat yang terinfeksi virus toksoplasma tidak memiliki gejala dan tidak menyadari bahwa mereka telah terinfeksi. Namun, beberapa orang lainnya memiliki tanda-tanda sakit seperti:
Sementara itu, pada orang dengan sistem kekebalan tubuh yang lemah seperti mengidap HIV/AIDS, kemoterapi dan baru menjalani transplantasi organ ada beberapa tanda-tanda yang perlu diperhatikan:
- Sakit kepala
- Kebingungan
- Koordinasi yang buruk
- Kejang
- Masalah paru-paru yang mungkin menyerupai tuberkulosis atau Pneumonia jiroveci Pneumocystis, infeksi oportunistik umum yang terjadi pada orang yang memiliki HIV/AIDS
- Penglihatan kabur yang disebabkan oleh peradangan parah retina (toksoplasmosis okular)
Infeksi toksoplasmosis juga bisa terjadi pada bayi yang ditularkan oleh ibu hamil yang sudah terinfeksi virus ini. Jika di trimester pertama Mama terkena virus toksoplasma, kemungkinan mengalami keguguran sangat besar. Untuk bayi yang lahir dari Mama yang mengidap toksoplasmosis, bisa menyebabkan masalah serius seperti:
- Kejang
- Hati dan limpa yang membesar/ bengkak
- Menguningnya kulit dan putih mata (penyakit kuning)
- Infeksi mata yang parah
Perlu diketahui, hanya sedikit kasus bayi baru lahir yang memiliki toksoplasmosis menunjukkan tanda-tanda penyakit saat lahir. Seringkali bayi yang terinfeksi tidak memiliki gejala tapi menyebabkan gangguan pendengaran hingga cacat mental.
5. Komplikasi virus toksoplasma

Dikutip dari Mayo Clinic, jika memiliki sistem kekebalan tubuh yang baik maka komplikasi toksoplasmosis sedikit kemungkinannya. Meskipun orang yang memiliki virus ini kadang menunjukkan gejala infeksi mata yang jika tidak diobati dapat menyebabkan kebutaan.
Perlu waspada jika memiliki sistem kekebalan tubuh yang lemah, karena toksoplasmosis dapat menyebabkan kejang dan penyakit yang mengancam jiwa seperti ensefalitis atau radang otak yang serius.
Sementara itu, untuk bayi baru lahir dengan toksoplasmosis bawaan dari Mamanya dapat memiliki komplikasi seperti gangguan pendengaran, kecacatan mental dan kebutaan dari lahir.
6. Cara mencegah terkena virus Toksoplasma

Ada beberapa tindakan pencegahan agar tidak terkena virus toksoplasma, yakni:
- Kenakan sarung tangan saat berkebun atau menggali tanah. Kenakan sarung tangan setiap kali bekerja di luar ruangan dan cuci tangan secara menyeluruh dengan sabun dan air sesudahnya.
- Jangan makan daging mentah atau kurang matang. Daging, terutama domba, daging babi dan daging sapi, dapat menjadi berkembang biang organisme toksoplasma. Jangan mencicipi daging sebelum dimasak sepenuhnya. Hindari daging mentah segar.
- Cuci peralatan dapur secara menyeluruh. Setelah menyiapkan daging mentah, cuci talenan, pisau dan peralatan lainnya dalam air panas dan sabun untuk mencegah kontaminasi silang makanan lain. Cuci tangan setelah mengolah daging mentah.
- Cuci semua buah-buahan dan sayuran. Gosok buah-buahan dan sayuran segar, terutama jika berencana untuk memakannya mentah. Kupas kulit bila memungkinkan.
- Jangan minum susu yang tidak dipasteurisasi. Susu yang tidak dipasteurisasi dan produk susu lainnya mungkin mengandung parasit toksoplasma.
Untuk pecinta kucing
Jika sedang hamil atau berisiko besar komplikasi toksoplasma, lakukan langkah-langkah berikut untuk melindungi diri sendiri:
- Pastikan kucing di rumah selalu sehat. Beri makan makanan kering atau kalengan dan bukan daging mentah. Kucing dapat terinfeksi setelah makan daging yang mengandung parasit.
- Hindari kontak dengan kucing liar. Kebanyakan kucing tidak menunjukkan tanda-tanda infeksi T. gondii, dan meskipun mereka menjalani uji infeksi toksoplasmosis perlu waktu hingga satu bulan untuk mendapatkan hasilnya.
- Ada orang lain yang membersihkan kotoran kucing di rumah. Jika tidak mungkin dilakukan, gunakan sarung tangan dan masker wajah untuk membuangnya. Kemudian cuci tangan dengan baik. Buang kotoran setiap hari sehingga virus toksoplasma tidak punya kesempatan untuk menular.
7. Bagaimana virus toksoplasma sebabkan radang otak?

Dikutip dari Harvard Health Publishing, sebagian besar orang sehat yang terkena virus ini tidak menyebabkan gejala dan penyakit yang parah. Namun orang dengan sistem kekebalan tubuh lemah, memiliki penyakit kronis, bayi baru lahir atau orang yang baru menjalani transplantasi organ sangat berisiko tinggi terjangkit infeksi toksoplasma.
Pada orang dengan kondisi daya tahan tubuh lemah, toksoplasmosis bisa menyebar ke seluruh tubuh sampai merenggut nyawa. Parasit toksoplasma juga bisa diam-diam hidup di dalam tubuh penderitanya, lalu suatu ketika aktif dan menyerang tubuh sampai menimbulkan penyakit parah. Situasi ini bisa berbahaya bagi pemilik daya tahan tubuh lemah. Pasalnya, salah satu komplikasinya menyebabkan radang otak atau ensefalitis.
Itulah tadi fakta seputar virus toksoplasma dan infeksi toksoplasmosis yang bisa menyebabkan radang otak hingga kematian. Semoga Mama dan Papa bisa lebih paham dengan virus toksoplasma dan komplikasinya yang bisa membahayakan kesehatan. Semoga arwah dari Barli Asmara bisa tenang di sana ya, Ma.














































